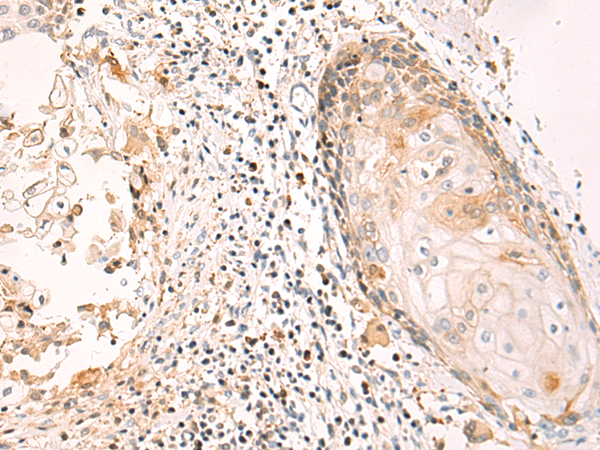

|
Background: |
Receptor for TNFSF12/TWEAK. Weak inducer of apoptosis in some cell types. Promotes angiogenesis and the proliferation of endothelial cells. May modulate cellular adhesion to matrix proteins. |
|
Applications: |
ELISA, IHC |
|
Name of antibody: |
TNFRSF12A |
|
Immunogen: |
Fusion protein of human TNFRSF12A |
|
Full name: |
TNF receptor superfamily member 12A |
|
Synonyms: |
FN14; CD266; TWEAKR |
|
SwissProt: |
Q9NP84 |
|
ELISA Recommended dilution: |
5000-10000 |
|
IHC positive control: |
Human esophagus cancer and Human tonsil |
|
IHC Recommend dilution: |
50-100 |

購物車
購物車 幫助
幫助
 021-54845833/15800441009
021-54845833/15800441009
